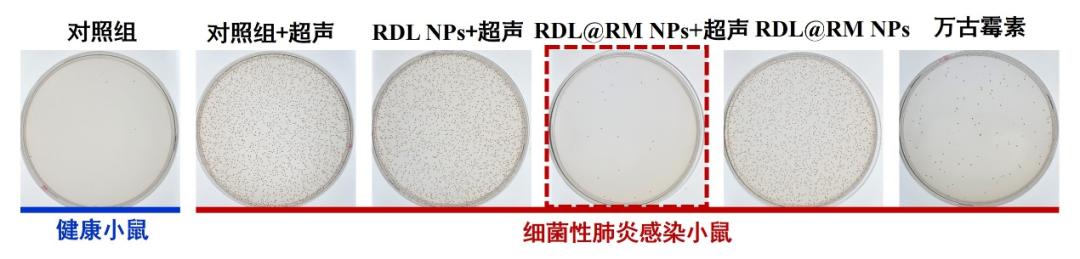

传统的光动力疗法依赖外部光源激发光敏剂,产生活性氧物种杀伤病原体,但可见光和近红外光的组织穿透深度不足2厘米,难以作用于深部感染病灶。
日前,中国科学院理化技术研究所最新开发了一种超声触发的仿生靶向纳米颗粒RDL@RM NPs,可通过超声触发与分子内化学发光共振能量转移,协同驱动原位循环光动力疗法,克服了传统光动力疗法组织穿透浅、疗效受限的挑战,为肺炎等深部感染的精准治疗提供了新思路。
01
设计新型光敏剂
研究团队以Ru(II)配合物为光敏核心,通过π共轭扩展引入竹红菌素衍生物,构建出高效I型光敏剂Ru-DMHC。
团队通过配位共价键,进一步将其与超氧阴离子自由基响应型化学发光供体,以2+2自组装策略整合为超分子光敏剂RDL,使两个配体之间展现出优异的光谱重叠。
这一设计策略有效缩短了供受体之间的距离,实现了高达97%的化学发光共振能量转移效率。

超分子光敏剂的设计和合成
02
原位循环治疗机制
在超声激活下,超分子光敏剂RDL可高效产生羟基自由基(∙OH)与超氧阴离子自由基(O2•-)。
超分子光敏剂RDL自身产生的O2•-,与炎症部位过表达的内源性O2•-共同作用,触发化学发光配体发射强荧光,进而激活Ru(II)基光敏剂受体,使其也产生大量∙OH与O2•-,从而形成∙OH持续生成的正反馈循环。
超声诱导的空化效应可显著增强化学发光强度,最终实现治疗。治疗由超声波和分子内的能量转移“双重驱动”,能够在病灶原位启动循环式的、由化学发光介导的光动力治疗。

高效活性氧产生机制
03
效果验证
通过杂化细胞膜外壳包覆策略,团队构建了仿生靶向纳米颗粒RDL@RM NPs。
该纳米颗粒可实现对小鼠肺部炎症部位的靶向和富集,进而通过化学发光介导的光动力治疗,有效根除深部缺氧组织中的病原体。
体内治疗效果
这一研究为超声触发的基于化学发光超分子光敏剂的开发,及其在深部细菌感染治疗中的应用提供了有力支撑。
来源:中国科学院理化技术研究所
责任编辑:曹旸